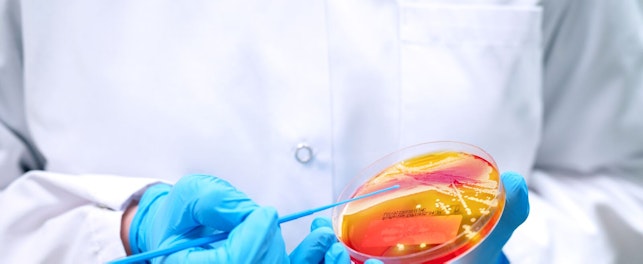

SGS, a principal empresa mundial em inspeção, verificação, testes e certificação, está reforçando seu papel estratégico na consolidação do mercado brasileiro de créditos de carbono.
Em um momento decisivo para a política climática do país, a empresa fortalece sua posição como um Órgão Independente de Validação e Verificação (VVB), garantindo que os projetos brasileiros atendam aos mais altos padrões internacionais de qualidade, rastreabilidade e transparência.
Nesse contexto, a SGS atua como parceira estratégica para governos, empresas e desenvolvedores de projetos, oferecendo um portfólio abrangente de serviços para validação, verificação e certificação de créditos de carbono e estoques de gases de efeito estufa.
Essas incluem auditorias baseadas em normas internacionais como Verra, Cercarbono (recentemente aprovada na Colômbia), Isometric, Puro e Social Carbon, além da verificação das emissões corporativas de gases de efeito estufa (ISO 14064), pegada de carbono do produto (ISO 14067) e neutralidade de carbono (ISO 14068).
Com essas aprovações, a SGS agora pode validar e verificar uma gama mais ampla de projetos de mitigação das mudanças climáticas e remoção de carbono em múltiplos setores, incluindo energia, indústria, agricultura, silvicultura, uso da terra, transporte, gestão de resíduos e captura e armazenamento de carbono.
"Nossas aprovações sob múltiplos padrões rigorosos reforçam o compromisso da SGS em oferecer serviços de verificação de alta qualidade que gerem impacto climático real. Empresas e investidores podem confiar que os créditos de carbono que validamos são cientificamente robustos, adicionais e mensuráveis"dito Francesca Cerchia, Chefe Global de Soluções para Clima e Sustentabilidade na SGS.
Por meio de sua iniciativa de sustentabilidade IMPACT NOW, a SGS integra a ação climática com a proteção da biodiversidade e a redução da poluição, garantindo que a validação do projeto de carbono esteja alinhada com metas mais amplas de impacto ambiental e social.

De acordo com Gustavo Venda, Gerente de Negócios de Sustentabilidade na SGS, a maturação do mercado verificado representa uma oportunidade histórica para o Brasil se posicionar como o polo latino-americano para créditos de carbono de alta qualidade."Órgãos independentes de auditoria como a SGS desempenham um papel essencial nesse processo, fornecendo a garantia técnica necessária para que cada ativo de carbono mantenha credibilidade, valor e reconhecimento global". ele disse.
Os clientes se beneficiam do acesso a créditos de carbono de alta integridade reconhecidos internacionalmente, maior credibilidade de mercado e a possibilidade de integrar créditos verificados em estratégias corporativas de neutralidade líquida. Plataformas transparentes como o EcoRegistry e o Isometric Registry da Cercarbono garantem o rastreamento seguro dos projetos e créditos verificados.
À medida que a regulamentação avança e a demanda por projetos verificados continua a crescer, o Brasil está bem posicionado para atrair novos investimentos em inovação, conservação ambiental e desenvolvimento sustentável, combinando competitividade econômica com compromisso climático.

Sobre a SGS
A SGS é a empresa líder mundial em testes, inspeção e certificação. Operamos uma rede de mais de 2.500 laboratórios e instalações comerciais em 115 países, com o suporte de uma equipe de 99.500 profissionais dedicados. Com mais de 145 anos de excelência em serviços, combinamos a precisão e a exatidão que definem as empresas suíças para ajudar as organizações a atingir os mais altos padrões de qualidade, conformidade e sustentabilidade.
Nossa promessa de marca, when you need to be sure, ressalta nosso compromisso com a confiança, integridade e confiabilidade, permitindo que as empresas prosperem com confiança. Temos orgulho de fornecer nossos serviços especializados por meio do nome SGS e marcas especializadas confiáveis, incluindo Brightsight, Bluesign, Maine Pointe e Nutrasource.
A SGS é negociada publicamente na SIX Swiss Exchange sob o símbolo SGSN (ISIN CH1256740924, Reuters SGSN.S, Bloomberg SGSN:SW).
Avenida Piracema 1341, Galpão Horizon,
06460-030,
Barueri, São Paulo, Brasil